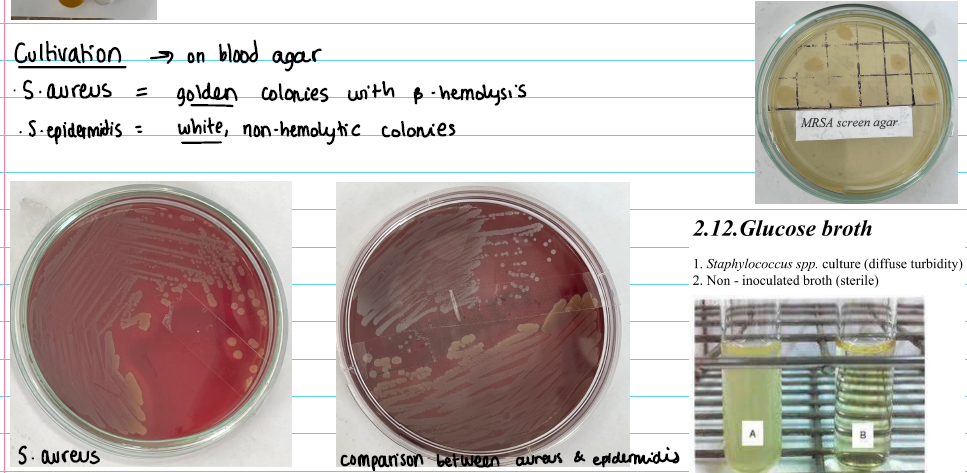
<p><strong>blood agar</strong></p><p>S. Aureus: golden with ß-hemolysis</p><p>S. epidermitis: white NO ß-hemolysis</p><p></p><p><strong>Glucose broth: </strong>turbidity</p><p></p><p><strong>MRSA Screen Agar: </strong>added antibiotics, if it growths - MRSA</p>

Staphylococcus spp.
1/8
There's no tags or description
Looks like no tags are added yet.
Name | Mastery | Learn | Test | Matching | Spaced | Call with Kai |
|---|
No study sessions yet.
9 Terms
Morphology
Shape: cocci
arranged in clusters
Staining
Gram +
Pathogenic factor
Exotoxins
Cultivation
blood agar
S. Aureus: golden with ß-hemolysis
S. epidermitis: white NO ß-hemolysis
Glucose broth: turbidity
MRSA Screen Agar: added antibiotics, if it growths - MRSA
Specimen
Cerebrospinal fluid
Sinus puncture
Pus secretion
Identification
Plasma coagulase test:
+S. aureus
-S.epidermidis

Symptoms
LOCAL:
Abscesses, furuncles (pus)
Impetigo
Systemic:
Fever and chills, Fatigue
Bacteremia / sepsis
Endocarditis
Osteomyelitis
Pneumonia
UTI
Toxin-related:
Food poisoning
Toxic shock syndrome
Antibiotics
No MRSA: ß-lactams
Penicillin allergy: Cephalosporins
MRSA: Vancomycin / Linezolid / Doxycyclin
CoNeg: Doxycyclin
Vaccine
NO VACCINE
(Only OM-85 bacterial lysates for respiratory infections)